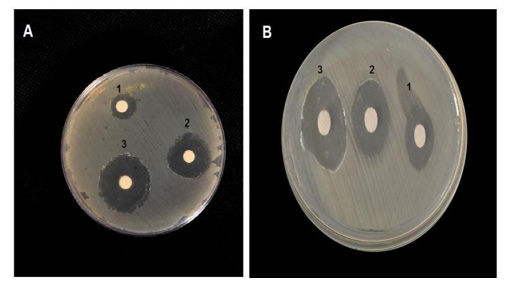

Research Article
Creative Commons, CC-BY
Antibacterial Potential of Cerium Oxide and Cobalt- Doped Cerium Oxide Against E. Coli and S. Aureus
*Corresponding author: Rehana Riaz, Department of Physics, International Islamic University, Islamabad, Pakistan.
Received: December 17, 2024; Published: December 20, 2024
DOI: 10.34297/AJBSR.2024.25.003309
Abstract
This research focuses on combating bacterial infections by synthesizing cerium oxide (CeO2) and modifying it with 3% and 5% zinc doping, along with 7% cobalt doping, using the co- precipitation method. Structural, morphological, optical, and antibacterial properties were systematically investigated. X-Ray Diffraction (XRD) revealed an increase in crystallite size from 12nm for pure cerium oxide to 13.42nm for 3% cobalt-doped cerium oxide after annealing. Scanning Electron Microscopy (SEM) confirmed agglomerated spheroidal structures for all samples. Diffuse Reflectance Spectroscopy (DRS) showed a widened energy band gap, from 2.76eV for pristine cerium oxide to 3.09eV for the annealed 7% cobalt doped cerium oxide, suggesting potential alterations in electronic properties. Antibacterial activity demonstrated that 7% cobalt doped cerium oxide exhibited the maximum zone of inhibition against Escherichia coli and Staphylococcus aureus, indicating superior antibacterial activity compared to other synthesized materials. Thus, this study showcases a tailored approach to cerium oxide nanoparticles, highlighting the significance of modifications for enhanced antibacterial applications. The findings in this research contribute to the development of advanced antibacterial agents, leveraging the unique properties of modified cerium oxide nanoparticles.
Keywords: Antibacterial activity, Cerium oxide, Co-precipitation, E. coli, S. auerus
Introduction
Nanoparticles are emerging in every field of life for various applications i.e. industries, energy storage, medicine and environment [1-4]. Nanotechnology has revolutionized medicine through nanoparticles for diagnostics, DNA sequencing, drug delivery systems and anti-bacterial activities [5]. Recent progress in nanotechnology has notably enhanced the management and spread of bacterial and microbial infections [6]. Recent advancements in nanotechnology have led to the creation of over 1814 nanoparticle- based medications, primarily utilizing metals and metal oxides such as gold, nickel, silver, iron, carbon, zinc, cerium, and more. These nanoparticles are gaining attention for their ability to selectively block metabolic pathways, interact with bactericidal activity, and combat drug-resistant bacteria [7-13].
Nanostructures can be synthesized via many techniques i.e. laser ablation, hydrothermal, sol-gel, and co-precipitation [14-17]. Co precipitation is a cheap, environmentally friendly and most commonly used chemical synthesizing method [18]. Cerium, a rare earth metal and the first element in the lanthanide series, exhibits a unique ability to exist in both the 3+ and 4+ oxidation states. Cerium oxide, also known as ceria, possesses a cubic fluorite-type oxide structure with cerium ions occupying the face and vertices, while oxygen ions fill the tetrahedral vacancies within the cubic unit cell [19,20]. Previous studies have demonstrated its antibacterial properties without the need for external stimulation [21-23]. Cerium oxide (CeO2) has garnered significant attention as an antibacterial agent due to its minimal or absent toxicity to mammalian cells, distinguishing it from other nano materials [24-26]. Renowned for its low toxicity, high stability, ductility, chemical reactivity, and potent oxidation catalytic capabilities, cerium oxide is a focal point in nanotechnology research, particularly for its potential in catalytic antioxidant applications. Also, cobalt is found to be effective in treating bacterial activities and cancer [27].
In this research, the antibacterial properties of E. coli and S. aureus are studied thoroughly. E. coli is a gram-negative bacterium that causes diarrheal sickness, whereas S. aureus is a gram-positive bacterium associated with skin and tissue infections. Recent research has shown that cerium oxide is effective in fighting these two bacteria [28,29]. Research conducted by Y.A. Syed prompt us to investigate 3wt%, 5wt% and 7wt% cobalt doped cerium oxide synthesized via co precipitation instead of hydrothermal synthesis to study the antibacterial activities of E. coli and S. aureus [30].
Experimental Section
Fabrication
The experimental technique utilized in this research was the co-precipitation technique. To synthesize cerium oxide nanoparticles and cobalt-doped cerium oxide nanoparticles, molar solutions of the starting materials were prepared. For cerium oxide nanoparticles, a 0.1M solution of cerium chloride hepta-hydrate was combined with a 0.3M solution of sodium hydroxide, resulting in a light-yellow colloidal suspension after 4hours of reaction time. The precipitates formed were washed thrice with distilled water and ethanol and then dried at 100°C for 3hours to obtain ceria (CeO2) nano powder. For cobalt-doped cerium oxide nanoparticles, three different molar concentrations of cobalt chloride salts (0.03M, 0.05M, and 0.07M) were prepared and added gradually to a stirred 0.1M cerium chloride hepta-hydrate solution. Sodium hydroxide was used as a precipitating agent to maintain pH during the process. The resulting pale-yellow colloidal solutions were aged at room temperature for 2days, followed by separation of the precipitates via centrifugation. These precipitates were washed several times with ethyl alcohol and distilled water to remove impurities, dehydrated, ground, and subjected to further characterization.
Antibacterial Activity
The effectiveness of newly synthesized Nano formulations against pathogenic bacteria causing various infections was assessed using the disc diffusion method. Pure strains of E. coli and S. aureus were isolated from clinical samples of infected patients. Cultures of these pure strains were grown overnight and inoculated into tubes of nutrient broth to achieve a final inoculum of 1.6x10^4 CFU ml-1 after 24hours of incubation at 37°C. To ensure even distribution, 10μl of the cultures were spread onto Muller-Hinton (MH) plates using a glass spreader. Sterile forceps were used to place discs containing equal concentrations (5μg/ml) of Nano formulations onto the MH plates. Additionally, different concentrations of Ce-Co Nano composite were tested against the pathogenic bacteria. After incubating the plates for 24hours at 37°C, the zone of inhibition was observed. All experiments were conducted in triplicate, with three independent experiments performed to confirm the findings.
Characterization
Structural analysis of thin films deposited on a glass substrate was conducted using an X-ray diffractometer (XPERT-3 with Cu Kα radiation), with the apparatus operating at a voltage of 40kV and a current of 40mA. The diffractometer had a wavelength of 1.540589Å. Morphological examination of nanostructures was carried out via scanning electron microscopy (JSM-6490) at an accelerating voltage of 20kV, with photos analyzed at a resolution of 1μm. Optical characteristics were assessed using a spectrophotometer (Schimadzu 2700-UV).
Results and Discussions
X-Ray Diffraction
The XRD technique was employed to analyze the crystal structure and morphology of the samples under investigation. This method enabled the examination of the crystal structure, crystallite size, and the impact of cobalt on cerium oxide nanoparticles. (Figure 1) shows the XRD patterns of four prepared samples, encompassing pure cerium oxide and cobalt-doped cerium oxide nanoparticles with dopant concentrations of 3 mole %, 5 mole %, and 7 mole %, were studied. The results revealed well-indexed and consistent peaks of cerium oxide nanoparticles, with no additional peaks corresponding to cobalt detected, indicating complete dissolution of cobalt into the ceria lattice. The single-phase cubic fluorite structure of ceria remained unchanged with doping. The observed peaks were identified at planes indexed by (111), (200), (220), (311), (222), (400), (331), and (420), in accordance with the JCPDS card no. 34-03940.
However, a minor reduction in size was observed with the incremental increase in cobalt doping concentration, denoted at 3, 5, and 7 moles %. A gradual peak shift towards lower angle side in the (111) plane was observed. This diminution in size was attributed to the substitution of smaller Co2+ ions having radii of 0.74Å in place of larger Ce4+ ions having atomic radii of 1.30Å within the CeO2 crystal lattice [31]. This decrease in particle size lead to peak broadening [32,33]. The crystalline sizes or average particles sizes were calculated using Debye-Scherer’s formula and their sizes were found to be lie in the range 7–13 nm that is in accordance with prior literature [34]. The calculated crystalline sizes are given in (Table 1) (Figure 1).
Fourier Transform Infrared Spectroscopy (FTIR)
Fourier Transform Infrared Spectroscopy (FTIR) was employed to analyze the structure of ceria nanoparticles and to identify any functional groups present in the prepared samples. The graphical representation in (Figure 2) illustrates the formation of ceria nanoparticles and the presence of chemical functional groups, as determined by FTIR spectroscopy. The FTIR analysis involved plotting a graph of transmittance against wave number. The ceria nanoparticles synthesized via the precipitation technique exhibited a prominent broad peak at 3385cm-1, corresponding to the O–H stretching mode of water molecules adsorbed on the surface of the nanoparticles [35].
Additionally, a peak at approximately 1356cm-1 was observed, attributed to the nitro (N-O) stretching vibrations, while peaks at around 1526cm-1 and 1079cm-1 were identified as stretching and bending vibrations of the interpolated C-O and N-O, respectively [36]. Furthermore, the vibrational band observed at 558 cm-1 was associated with the O-Ce-O stretching mode of vibration [37]. These findings collectively confirm the successful synthesis of cerium oxide nanoparticles via the co-precipitation technique. The obtained spectra clearly indicate that the NO and OH bending nature increased with increasing the Co-doping concentration in steps of 3,5 and 7 mole %. Hence, we get a clear picture about the chemical structure and other functional groups present in prepared samples (Figure 2).
Scanning Electron Microscopy (SEM)
Scanning electron microscopy was done for examining morphology of as prepared samples of Ceria nano particles. A suitable scale of 500nm was chosen in order to get a clear picture of effect of doping on ceria nano powders. The obtained SEM micrographs exposed the spherical and agglomerated nature of nanoparticles. It was observed from (Figures 3) that the morphology of the nanoparticles exhibited variation depending on the doping percentage of the dopant. With the increase in doping concentration the sizes of the Nano particles decreased and agglomeration increases. It is also clear from the SEM images of synthesized cobalt doped CeO2 samples were porous in nature (Figure 3).
Antimicrobial Activity
The antimicrobial efficacy of various synthesized combinations was assessed using the disc diffusion method against resistant strains of E. coli and S. aureus. In this study, three compounds were investigated, and the nano composite with a 7 mole % doping concentration exhibited the highest efficiency, characterized by a zone of inhibition measuring 23mm ±0.67, as detailed in (Tables 2,3). The observed zones of inhibition and their corresponding antibacterial activity patterns suggest the potential of these compounds as alternative therapeutic agents against challenging infections that pose difficulties for current treatment strategies. (Figure 4) illustrates the antibacterial activity of pure cerium oxide nanoparticles against both selected pathogens, while (Figure 5) depicts the impact of the three doped materials on determining effective antibacterial activity (Figure 4) (Figure 5) (Table 2).
Diffuse Reflectance Spectroscopy
Diffuse reflectance spectroscopy was performed to measure optical properties including reflectance, transmittance and band gap. Reflectance spectra of all samples of cerium oxide with pure cerium oxide and different doping concentration of cobalt were investigated in the wavelength from 220nm to 800nm at room temperature. UV–Vis transmittance spectra of pure ceria nanoparticles and different concentrations of cobalt-doped cerium nanoparticles is shown in (Figure 6) spectrum analysis showed a decrease in transmittance in visible region by increasing dopant concentration. These results recommended that the transmittance depends on the particle dimensions and the combinations of the particles [38]. This property of ceria nanoparticles can be utilized as UV shield due to increase of UV light absorption and visible light transmittance property [39] (Table 3) (Figure 6).
The optical band gap of the powdered samples was measured by DRS (Diffuse Reflectance Spectroscopy) in UV-Visible range. The optical band gap of samples was determined using Tauc method [40]. In order to investigate band gap of as prepared samples Kubelka- Munk function was found from the DRS Measurements. Kubelka- Munk transform gives a relationship between incident photon energy (hѵ) and bandgap energy (Eg) which is given in equation 4.2:[41].
F(R) = (1-R)2/2R
F(R) ℎ𝑣 = (ℎ𝑣 - 𝐸𝑔) n
where h is Planck constant, F(R) is the absorption coefficient, Eg represents band gap and A represent proportionality constant. The exponent n represents the nature of electronic transition. Direct or indirect transitions can be obtained by substituting different values of n. For direct transition n is substituted as 2 and for indirect transitions n is equal to ½. In order to do this the value of the optical band gap was obtained by linearly extrapolating the linear portion to y=0. The function of (F(R)hν)2 vs photon energy for cerium oxide with different concentration of cobalt is given in (Figure 7) The estimated optical band gap of ceria nanoparticles was found to be 2.76eV with different concentrations of cobalt (i.e. 0.03 mole%, 0.05 mole %, 0.07 mole %) was found to be 2.92eV, 3eV, 3.05eV respectively (Figure 7). The band gap values clearly indicate the rise of band gap which can be explained as the captivity of electrons and holes in between valence and conduction band with decrease in particle size [42,43] (Figure 7).
Conclusion
In conclusion, the co-precipitation synthesis and modification of cerium oxide nanoparticles, incorporating cobalt doping (3% and 5%) and 7%, exhibit promise in the treatment of bacterial infections. The increased crystallite size, particularly in 7% cobalt doped cerium oxide post-annealing, signifies structural improvements for enhanced stability. Scanning electron microscopy confirms non uniform agglomerated spheroidal structures. Diffuse reflectance spectroscopy indicates shifts in the energy band gap, influencing optical properties. Antibacterial assessments highlight the superior efficacy of 7% cobalt doped cerium oxide, emphasizing its potential in augmenting antibacterial properties. These findings underscore the potential of tailored cerium oxide nanoparticles for advanced antibacterial applications, warranting further exploration in this dynamic field.
Acknowledgement
None.
Conflict of Interest
None.
References
- Imran Ali, Changsheng Peng, Zahid M Khan, Muhammad Sultan, Iffat Naz, et al. (2019) Removal of crystal violet and eriochrome black T dyes from aqueous solutions by magnetic nanoparticles biosynthesized from leaf extract of Fraxinus Chinensis Roxb. Polish Journal of Environmental Studies 28(4): 2027-2040.
- Shama Sehar, Iffat Naz, Irum Perveen, Safia Ahmed (2019) Superior dye degradation using SnO 2-ZnO hybrid heterostructure catalysts. Korean Journal of Chemical Engineering 36(1): 56-62.
- Benjamin Trump, Danail Hristozov, Timothy F Malloy, Igor Linkov (2018) Risk associated with engineered nanomaterials: Different tools for different ways to govern. Nano Today 21: 9-13.
- Blanche Collin, Emily Oostveen, Olga V Tsyusko, Jason M Unrine (2014) Influence of natural organic matter and surface charge on the toxicity and bioaccumulation of functionalized ceria nanoparticles in Caenorhabditis elegans. Environmental science technology 48(2): 1280-1289.
- Emerich DF, CG Thanos (2003) Nanotechnology and medicine. Expert opinion on biological therapy 3(4): 655-663.
- Ahmadi Shadmehri A, F Namvar (2020) A review on green synthesis, cytotoxicity mechanism and antibacterial activity of Zno-NPs. Journal of Research in Applied and Basic Medical Sciences 6(1): 23-31.
- Karli Gold, Buford Slay, Mark Knackstedt, Akhilesh K Gaharwar (2018) Antimicrobial activity of metal and metal‐oxide based nanoparticles. Advanced Therapeutics 1(3): 1700033.
- Gu Xiao, Xu Zhixiang, Gu Lipeng, Xu Huayu, Han Fengxia, et al. (2021) Preparation and antibacterial properties of gold nanoparticles: A review. Environmental Chemistry Letters 19(1): 167-187.
- Ahghari MR, V Soltaninejad, A Maleki (2020) Synthesis of nickel nanoparticles by a green and convenient method as a magnetic mirror with antibacterial activities. Scientific reports 10(1): 12627.
- Saddam Saqib, Muhammad Farooq Hussain Munis, Wajid Zaman, Fazal Ullah, Syed Nasar Shah, et al. (2019) Synthesis, characterization and use of iron oxide nano particles for antibacterial activity. Microscopy research and technique 82(4): 415-420.
- Qi Xin, Hameed Shah, Asmat Nawaz, Wenjing Xie, Muhammad Zain Akram, et al. (2019) Antibacterial carbon‐based nanomaterials. Advanced Materials 31(45): e1804838.
- Getie S, Abebe Belay Gemta, Chandra Reddy AR, Zerihun Belay (2017) Synthesis and characterizations of zinc oxide nanoparticles for antibacterial applications. J Nanomed Nanotechnos 8(004).
- Xiaomei Liu, Jingchun Tang, Lan Wang, John P Giesy (2018) Mechanisms of oxidative stress caused by CuO nanoparticles to membranes of the bacterium Streptomyces coelicolor M145. Ecotoxicology and environmental safety 158: 123-130.
- Darr JA, Jingyi Zhang, Neel Makwana, Xiaole Weng (2017) Continuous hydrothermal synthesis of inorganic nanoparticles: applications and future directions. Chemical reviews 117(17): 11125-11238.
- Parashar M, VK Shukla, R Singh (2020) Metal oxides nanoparticles via sol–gel method: a review on synthesis, characterization and applications. Journal of Materials Science: Materials in Electronics 31(2): 3729-3749.
- Mascolo MC, Y Pei, TA Ring (2013) Room temperature co-precipitation synthesis of magnetite nanoparticles in a large pH window with different bases. Materials 6(12): 5549-5567.
- Myungjoon Kim, Saho Osone, Taesung Kim, Hidenori Higashi, Takafumi Seto, et al. (2017) Synthesis of nanoparticles by laser ablation: A review. KONA Powder and Particle Journal 34: 80-90.
- Świder J, Michal Swietoslawski, Marcin Molenda, R Dziembaj (2014) A novel concept for the synthesis of nanometric LiFePO4 by co-precipitation method in an anhydrous environment. Procedia Engineering 98: 36-41.
- Anirban S, T Paul, A Dutta (2015) Vacancy mediated ionic conduction in Dy substituted nanoceria: a structure–property correlation study. RSC Advances 5(62): 50186-50195.
- Shin Tsunekawa, Ryoji Sahara, Yoshiyuki Kawazoe, Atsuo Kasuya (2000) Origin of the blue shift in ultraviolet absorption spectra of nanocrystalline CeO2− x particles. Materials transactions JIM 41(8): 1104-1107.
- Yashu Kuang, Xiao He, Zhiyong Zhang, Yuanyuan Li, Haifeng Zhang, et al. (2011) Comparison study on the antibacterial activity of nano-or bulk-cerium oxide. Journal of nanoscience and nanotechnology 11(5): 4103-4108.
- Mushtaq A Dar, Rukhsana Gul, Ponmurugan Karuppiah, Naif A Al Dhabi, Assim Alfadda, et al. (2022) Antibacterial activity of cerium oxide nanoparticles against ESKAPE pathogens. Crystals 12(2): 179.
- Jessica T Dahle, Yuji Arai (2015) Environmental geochemistry of cerium: applications and toxicology of cerium oxide nanoparticles. International journal of environmental research and public health 12(2): 1253-1278.
- Roy W Tarnuzzer, Jimmie Colon, Swanand Patil, Sudipta Seal (2005) Vacancy engineered ceria nanostructures for protection from radiation- induced cellular damage. Nano letters 5(12): 2573-2577.
- Yi Yang Tsai, Jose Oca Cossio, Kristina Agering, Nicholas E Simpson, Mark A Atkinson, et al. (2007) Novel synthesis of cerium oxide nanoparticles for free radical scavenging 2(3): 325-332.
- Laura De Marzi, Antonina Monaco, Joaquin De Lapuente, David Ramos, Miquel Borras, et al. (2013) Cytotoxicity and genotoxicity of ceria nanoparticles on different cell lines in vitro. International journal of molecular sciences 14(2): 3065-3077.
- Shahanavaj Khan, Anees A Ansari, Abdul Arif Khan, Rehan Ahmad, Omar Al Obaid, et al. (2015) In vitro evaluation of anticancer and antibacterial activities of cobalt oxide nanoparticles. JBIC Journal of Biological Inorganic Chemistry 20: 1319-1326.
- G Poongodi, P Anandan, R Mohan Kumar, R Jayavel (2015) Studies on visible light photocatalytic and antibacterial activities of nanostructured cobalt doped ZnO thin films prepared by sol–gel spin coating method. Spectrochimica Acta Part A: Molecular and Biomolecular Spectroscopy 148: 237-243.
- Darr JA (2017) Continuous hydrothermal synthesis of inorganic nanoparticles: applications and future directions. Chemical reviews 117(17): 11125-11238.
- YA Syed Khadar, A Balamurugan, VP Devarajan, R Subramanian, S Dinesh Kumar, et al. (2019) Synthesis, characterization and antibacterial activity of cobalt doped cerium oxide (CeO2: Co) nanoparticles by using hydrothermal method. Journal of Materials Research and Technology 8(1): 267-274.
- A Akbari Fakhrabadi, R Saravanan, M Jamshidijam, RV Mangalaraja, MA Gracia, et al. (2015) Preparation of nanosized yttrium doped CeO2 catalyst used for photocatalytic application 19(5): 505-510.
- T Guo, P Nikolaev, A Thess, DT Colbert, RE Smalley, et al. (1995) Catalytic growth of single-walled manotubes by laser vaporization 243(1- 2): 49-54.
- Inaba H, H Tagawa (1996) Ceria-based solid electrolytes 83(1-2): 1-16.
- S Rengaraj, Seung Hyeon Moon (2002) Kinetics of adsorption of Co (II) removal from water and wastewater by ion exchange resins 36(7): 1783-1793.
- Mawlood Maajal Ali, Hadeel Salih Mahdi, Azra Parveen, Ameer Azam (2018) Optical properties of cerium oxide (CeO2) nanoparticles synthesized by hydroxide mediated method. AIP Conference Proceedings 1953(1).
- Malatesh S Pujar, Shirajahammad M Hunagund, Vani R Desai, Shivaprasadgouda Patil, Ashok H Sidarai, et al. (2018) One-step synthesis and characterizations of cerium oxide nanoparticles in an ambient temperature via Co-precipitation method. AIP Conference Proceedings 1942(1).
- Prabaharan, D.M.D.M (2016) Structural, optical, morphological and dielectric properties of cerium oxide nanoparticles. 19(2): 478-482.
- Tsugio Sato, Toshihiko Katakura, Shu Yin, Tsuyoshi Fujimoto, Shinryo Yabe, et al. (2004) Synthesis and UV-shielding properties of calcia-doped ceria nanoparticles coated with amorphous silica. Solid State Ionics 172(1-4): 377-382.
- Shinryo Yabe, Mika Yamashita, Shigeyoshi Momose, Kazuyuki Tahira, Sakae Yoshida, et al. (2001) Synthesis and UV shielding properties of metal oxide doped ceria via soft solution chemical processes. International Journal of Inorganic Materials 3(7): 1003-1008.
- Tauc J, R Grigorovici, A Vancu (1966) Optical properties and electronic structure of amorphous germanium. 15(2): 627-637.
- Jazmín Calvache Muñoz, Fabiola A Prado, Jorge E Rodríguez Páez (2017) Cerium oxide nanoparticles: Synthesis, characterization and tentative mechanism of particle formation. 529: 146-159.
- Chenguo Hu, Zuwei Zhang, Hong Liu, Puxian Gao, Zhong Lin Wang, et al. (2006) Direct synthesis and structure characterization of ultrafine CeO2 nanoparticles. Nanotechnology 17(24): 5983-5987.
- Saurabh Tiwari, Nivedha Balasubramanian, Sajal Biring, Somaditya Sen (2018) Synthesis, structure and characterization of Co doped CeO2 nanoparticles. In IOP Conference Series: Materials Science and Engineering.

We use cookies to ensure you get the best experience on our website.